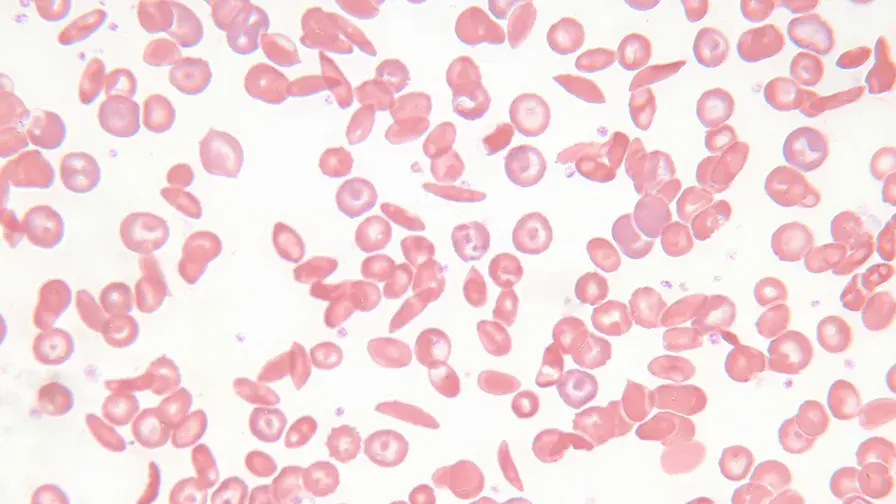
Cellules

Mis à jour le 10/02/2025
Hématopoïèse clonale et pré-leucémie dans la maladie de Fanconi
L’équipe du service d’hématologie biologique de l’hôpital Saint-Louis AP-HP, du Centre de Référence Maladies Rares « Aplasie Médullaire », de l’Inserm et d’Université Paris Cité, coordonnée par le Pr Jean Soulier, a retracé les mécanismes aboutissant à une hématopoïèse clonale puis à une leucémie aiguë par l’étude d’une vaste cohorte de patients atteints de maladie de Fanconi.Ces travaux ont fait l’objet d’une publication le 2 février 2023 dans la revue Cell Stem Cell.
La maladie de Fanconi (Fanconi anemia) est un syndrome génétique touchant la réparation de l’ADN, se manifestant par une insuffisance médullaire dans l’enfance et une forte prédisposition aux cancers1 Un tiers des patients développe une leucémie aiguë avant l’âge de 30 ans.
Une cohorte de 335 patients atteints de maladie de Fanconi suivis dans le réseau français des aplasies médullaires a été étudiée.
Des analyses cliniques, génomiques et fonctionnelles ont été menées chez les patients présentant une évolution clonale ce qui a permis de mettre en évidence une hématopoïèse clonale pré-leucémique2 associée à l’acquisition d’une trisomie du bras long du chromosome 1.
L’équipe a montré, grâce à plusieurs modèles expérimentaux in vitro et in vivo, que l’amplification par dosage génique d’un gène appelé MDM4, inhibiteur de p53 était responsable cette hématopoïèse clonale. La survenue ultérieure de plusieurs lésions additionnelles provoque ensuite la transformation en leucémie aiguë.
Ce modèle fournit un canevas pour la compréhension de la survenue de leucémies secondaires dans un contexte d’ADN endommagé. Ces travaux permettent aussi de caractériser finement le stade de la maladie chez chaque patient afin d’adapter au mieux le traitement, en particulier les indications d’allogreffe de moelle, pour prévenir les leucémies.
Un modèle préclinique a montré l’efficacité d’un traitement ciblant MDM4 sur les cellules porteuses de la trisomie 1q, suggérant des perspectives de thérapie ciblée en combinaison avec la greffe de moelle.

